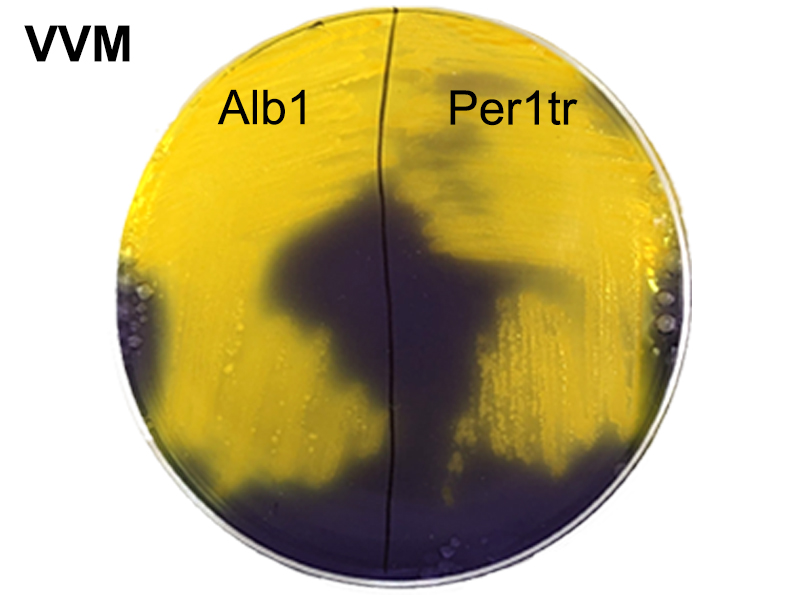

A sampling in the Albufera this November shows the presence of Vibrio vulnificus, a pathogen typical of warm areas. Climate change is real and is present in our daily lives.
Although the weather was not good, on 9 November 2022 our group went to the Albufera of Valencia to sample, with the aim of finding our study pathogen: Vibrio vulnificus (hereinafter, V. vulnificus).
V. vulnificus is a aquatic pathogenic bacterium that lives in brackish areas of warm climate, but due to climate change, it is spreading to more temperate areas such as our Mediterranean Sea. This bacterium normally infects fish, but it can become zoonotic, that is, it can affect humans. For all these reasons, the study of this pathogen is of vital importance for the protection of native animals in our surroundings, as well as to prevent clinical cases.
Strains of this bacterium had already been found in the Ebro Delta, so we decided to visit our main site, the Albufera, to carry out a search. And what a surprise we got! Not only did we find it in the lake, but also in one of its gorges, specifically in the Perellonet gorge.
So what did we do? We simply drank water from both the Albufera lake and the Perellonet gorge. We then went back to the laboratory and filtered the water (under aseptic conditions), to concentrate as much as possible.
The filters were then incubated in a culture medium called APW (Alkaline Peptone Water) with 1.5% sodium chloride; this medium favours the growth of V. vulnificus. Incubation lasted about 6 hours, followed by seeding on VVM and TCBS plates (the former medium is specific to V. vulnificus, while the latter is specific to V. cholerae).
The next day, growth was seen on both plates. In the case of VVM (panel A of the figure), the colonies of our study pathogen appear yellow; as for the TCBS culture (panel B of the figure), the colonies appear green.

Once a bacterial colony had been isolated from the VVM media of the Albufera and the Perellonet area, the presence of V. vulnificus was identified (and corroborated) using the API 20e strip (panel C of the figure); this technique allows us to identify enteric bacteria. And to our surprise, we did indeed find our pathogen in our Terreta!
To honour the place where we isolated them, we have named them Alb1 (after l'Albufera) and Per2tr (after Perellonet).
Good news for the group: we have new strains to study, and from the Terreta! However, if we get serious, this is obviously not good news. Climate change, the global warming we hear so much about, is real, and so real! Micro-organisms that inhabit warm areas are moving, reaching areas where, as we said before, they were more temperate. And "were" and not "are" because of rising temperatures around the globe.
We need global awareness of the reality of climate change, and we all need to fight together to protect and save our planet.
Images: